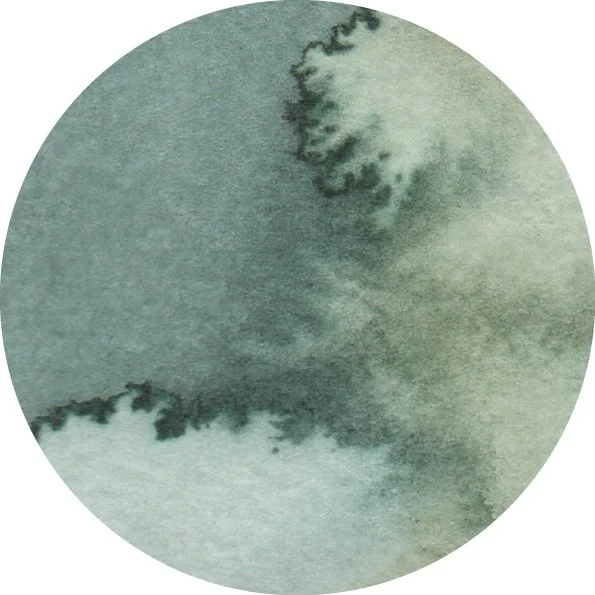

The Studio Vibe Membership
A calm, creative space to paint, learn, and grow inside my real studio.
The Studio Vibes Membership (The SVM) is a monthly creative space designed for anyone who wants to slow down, paint with intention, and build a confident watercolor practice.
All the content is filmed inside my actual studio — filled with natural light, high ceilings, and a calm atmosphere — so you can feel the space as you learn.
Whether you're a beginner taking your first brushstrokes, or an experienced artist looking to deepen your practice, The SVM gives you structure, inspiration, and a peaceful place to return to every month.
Learn more about the membership
These are the Frequently Asked Questions:
Is this a beginners watercolor membership?
The membership welcomes all levels. You will find from beginners projects and tips to intermediate and advance projects. We will cover first steps, like a beginners watercolor basic kit, to advanced watercolor techniques. First steps, water control, colour mixing and a long etc.
What will I find in it?
You will find from beginners projects to advanced ones. Recommended supplies for all levels, tips to look after your materials, differences between materials (i.e.cellulose paper vs cotton paper). All laid out in three sections, The Studio, The Lab and The Library, in video and in blog article format, properly tagged so that you can easily find what it is you are looking for.
What will I learn?
You will learn from basic watercolor techniques to advanced ones, and everything in between. My goal is to create a calm space where you can learn at your own pace. Everything from techniques to tips and tricks that will help you in your watercolor practice.
What do I do once I have paid?
When you proceed to payment, you will create your personal login information.User and password. Those details will grant you immediate access to the membership and all the content created up to that date and whatever is created during your enrollment.
When do I get access to the content once I join?
Once you join you will get immediate access to all the content created until then.
How often is the content updated?
You will get monthly new content, uploaded every two weeks, usually on Fridays. This monthly content will always include a video recorded project.
If I decide to cancel my subscription, can I? How?
You can cancel at any time. You just need to pop over to your account and click on cancel subscription. Easy peasy.
Why should I join this membership?
First of all because it would mean the world to me:) If you are reading this far, I would just like to take a moment to thank you for your interest in my membership.
Secondly because teaching is my passion. I really love it. I enjoy preparing the classes and viewing my students evolving, improving their skills and loving watercolor more and more. And I’m good at teaching! :) If you are interested in seeing me in action, here is the link to the free class I have available for you. I hope you like the class and your instructor;)
What if I don´t like it?
I am sure you will, but if that is the case you can unsubscribe at any time. No questions asked. I can not offer a refund as once you pay you get full access to the content in the membership. Just make sure to unsubscribe. Head to your account and cancel your subscription from there.
What is the refund policy?
Because this is a digital product and you will access to a ton of content immediately I cannot offer a full refund. Nevertheless, if you contact me within the 7 days from joining, I can provide a refund. A happy customer is the best customer!
How can I contact you? I still have questions
Shoot me an e mail to kristina@kristinadelbano.com with your questions and I will get back to you asap. Thanks!
“It all begins with an idea. Maybe you want to launch a business.”
Keith Finley
“It all begins with an idea. Maybe you want to launch a business.”
Monet Goode
“It all begins with an idea. Maybe you want to launch a business.”
Channing Lee